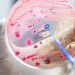
‘Alarming’ one in five deaths due to blood poisoning

Amy Slogrove, Stellenbosch University and Kathleen M. Powis, Harvard Medical School
In many countries with a high HIV prevalence, at least 95% of children born to mothers living with HIV remain HIV-uninfected. This is due to the success of wide-scale provision of antiretroviral therapy to mothers with HIV to prevent transmission to their children during pregnancy, labour or breastfeeding.
Children born to mothers with HIV are known as HIV-exposed. While many children who are HIV-exposed and also HIV-uninfected are growing and developing well, some face greater risks.
They are more likely to be hospitalised with severe infections when they are infants. They are also at higher risk of dying before their second birthday. And the risks are even higher when babies who are HIV-exposed and uninfected are born early, with low weight at birth, or to mothers with severe HIV disease.
This is why it’s important to know as much as possible about this population of children, how many there are and where they are in the world.
Every year the United Nations provides key estimates related to the HIV epidemic. These usually include the number of people living with HIV, the number of new infections and the number of people receiving treatment. In 2018 for the first time, estimates for children aged 0-14 years who were HIV-exposed and uninfected were included.
We used the most recent UNAIDS estimates, published in July 2019, to calculate the share of each country in the global total of children who are HIV-exposed and uninfected. These estimates allow us to report on changes in the size of this population and trends over time, between 2000 and 2018. And we calculated the percentage of children who are HIV-exposed uninfected in countries with the highest HIV burden.
What we found
We found that in 2018 there were 14.8 million children who were HIV-exposed and uninfected around the world. This population has more than doubled from 6.7 million in 2000.
Ninety percent of all these children are from sub-Saharan Africa. Strikingly, half of all children who are HIV-exposed and uninfected come from just five countries – South Africa, Uganda, Mozambique, Tanzania and Nigeria.
South Africa alone accounts for 3.5 million or 24% of all children who are HIV-exposed and uninfected.
Equally alarming is that in four southern African countries more than 20%, or at least one in every five children, is HIV-exposed and uninfected – Eswatini (32%), Botswana (27%), South Africa (22%) and Lesotho (21%).
What next
The substantial global population of children who are HIV-exposed and HIV-uninfected needs a coordinated strategy to reduce HIV exposure in children and to ensure their optimal health and wellbeing. Informed by these estimates, we propose a coordinated global strategy for improving their health outcomes.
This strategy requires collaboration from governments and their partners, including multilateral organisations, researchers and funders. It must be built on a strong foundation of dialogue with families and communities affected by HIV, who have seldom been consulted on the wellbeing of their children when they are HIV-uninfected.
Our proposed strategy has three pillars:
- First, to reduce the number of adolescent girls and women newly infected with HIV and to reduce unintended pregnancies in adolescent girls and women living with HIV. The number of children who are HIV-exposed is determined by the number of pregnant women living with HIV, which has remained unchanged at 1.3 million globally every year since 2000.
- Second, to keep mothers with HIV on lifelong antiretroviral therapy to ensure they stay well and don’t transmit HIV during pregnancy and breastfeeding. Countries with a high burden of HIV also need systems to continually evaluate the safety of this therapy.
- Third, to ensure that research covers the geographical regions that are most affected. Exposure to HIV and to antiretroviral drugs during pregnancy has been well researched in high-income countries. But their HIV prevalence is low and other factors very different from the low- and middle-income countries where most of the children exposed to HIV are found. For instance, child mortality, preterm birth, infectious diseases and malnutrition occur far more often in low- and middle-income countries.
There are large numbers of children who are HIV-exposed and HIV-uninfected in southern Africa – and they are not surviving and thriving as well as children born to women without HIV. There is an urgent need in this region to find solutions enabling all children to reach their developmental potential and contribute fully to their communities.![]()
Amy Slogrove, Senior lecturer in Paediatrics and Child Health, Stellenbosch University and Kathleen M. Powis, Assistant Professor, Harvard Medical School
This article is republished from The Conversation under a Creative Commons license. Read the original article.